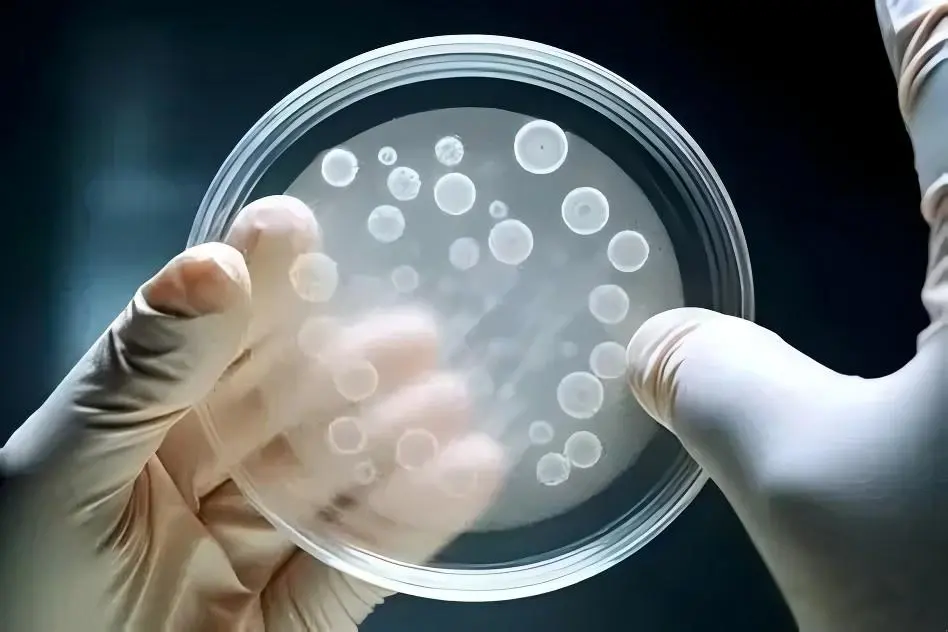
浮游菌检验

GB/T 16293-2025:医药工业浮游菌测试方法新标准解读
发布时间:2025-11-19 浏览次数:742
一、前言
近期国家标准委正式发布新版GB/T 16293-2025《医药工业洁净室(区)浮游菌的测试方法》,将于2026年11月1日正式实施。对于微生物检测行业来说,大家有哪些相关的变化和准备要做呢,下面对该文件进行解读并提供应对策略。
二、准备
统一的实施日期:GB/T 16293-2025将在 2026年11月1日 正式实施。
关注关键变化:重点关注采样计划(点数、位置、量) 和培养程序的具体更新,这对日常监测工作的影响最为直接。
获取正式文本:通过官方渠道购买正式文本,以确保获取最准确、完整的信息。
联动更新文件:洁净室环境监测是一个系统工作,建议同时审查并更新相关的质量文件和操作规程,如《浮游菌测试程序》等,确保与新版标准要求保持一致。
三、变化
3.1.增加了浮游菌采样器工作原理
3.2.增加了培养基的要求
3.2.1.2025版:一般选择胰酪大豆胨琼脂培养基(TSA),必要时可加入适宜的中和剂。当监测结果有疑似真菌或考虑季节因素影响时,可增加沙氏葡萄糖琼脂培养基(SDA)。应符合《中华人民共和国药典 2025年版 四部》9203相关要求。
3.3.采样位置修改
3.3.1.2025版:在进行洁净室(区)确认及监测时,应基于风险评估确定采样点数目及位置(含水平及垂直位置)。
3.3.2.2010版:工作区采样点位置离地0.8m~1.5m左右(略高于工作面)。
3.3.3.解读:这次修改给采样高度进行了解放,原来的采样高度在日常使用时很不方便,有很多公司都是评估后直接放在地面采样的。
3.4.更改了培养计数要求;
3.4.1 2025版:对于环境微生物种群不确定的情况,可在20℃~25℃培养3d~5d后再转移至30℃~35℃培养2d~3d,或先在30℃~35℃培养2d~3d后再转移至20℃~25℃培养3d~5d。当采用沙氏葡萄糖琼脂培养基(SDA)时,培养温度为20℃~25℃,时间为5d~7d。宜根据环境污染微生物历史数据及种群特性调整培养方案。
3.4.2. 2010版:采用大豆酪蛋白琼脂培养基(TSA)配制的培养皿经采样后,在30℃~35℃培养箱中培养,时间不少于2d;采用沙氏培养基(SDA)配制的培养皿经采样后,在20℃~25℃培养箱中培养,时间不少于5 d。
3.6.3.解读:目前比较推荐用TSA进行高低温培养,先高温48-72H,再低温48-72H,总培养时间不得少于5天(USP<1116>里说和人体相关的革兰氏阳性菌不太适合先低温培养 In the absence of confirmatory evidence, microbiologists may incubate a single plate at both a low and a higher temperature. Incubating at the lower temperature first may compromise the recovery of Gram-positive cocci that are important because they are often associated with humans.)。
3.5.表1浮游菌最小采样点数目改变
3.5.1解读:建议和悬浮粒子的点位数量保持一致,方便日常操作,洁净室初始验证时先测悬浮粒子确定级别,再确定点位位置和数量。
3.6.增加了不同洁净级别的最小采样量要求

3.6.1解读:这次的更改比较符合目前的实际要求,比较合理,可以用作日常监测时候使用。
3.7 删除了“结果评定” 相关章节
3.8 删除了“日常监控” 章节
3.9 删除了“洁净室(区) 采样点布置” 章节
3.10 删除了“培养基的灭菌及准备”章节
本文由环凯转载自“Micro视野”公众号,版权归原作者所有,仅供学习参考,如有侵权请联系删除!
